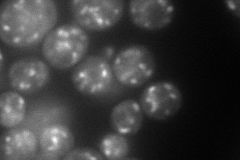
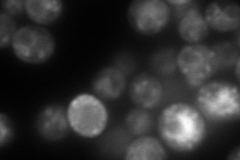

View description
GTPase, Ras-like GTP binding protein involved in the secretory pathway, required for fusion of endosome-derived vesicles with the late Golgi, maturation of the vacuolar carboxypeptidase Y; has similarity to the human GTPase, Rab6
Localization:
Intensity:
Fold change:
Significance:
-
C’ GFP library in SD

cytosol40.5 -
N' NOP1pr-GFP in SD
punctate99.2199 -
N' TEF2pr-mCherry in SD
ER,punctate217.997 -
N' NATIVEpr-GFP in SD

punctate45.8368 -
N' TEF2pr-VC and Cyto-VN in SD

ER,punctate45.2705 -
C’ GFP library in SD+DTT

cytosol58.051.43Yes -
C’ GFP library in SD+H2O2

cytosol29.430.72No -
C’ GFP library in Starvation Media

cytosol50.841.25No -
C’ GFP library on the background of Pup2-DaMP

cytosol -
C’ GFP library on the background of CCT mutant

cytosol60.95241.50486Yes
